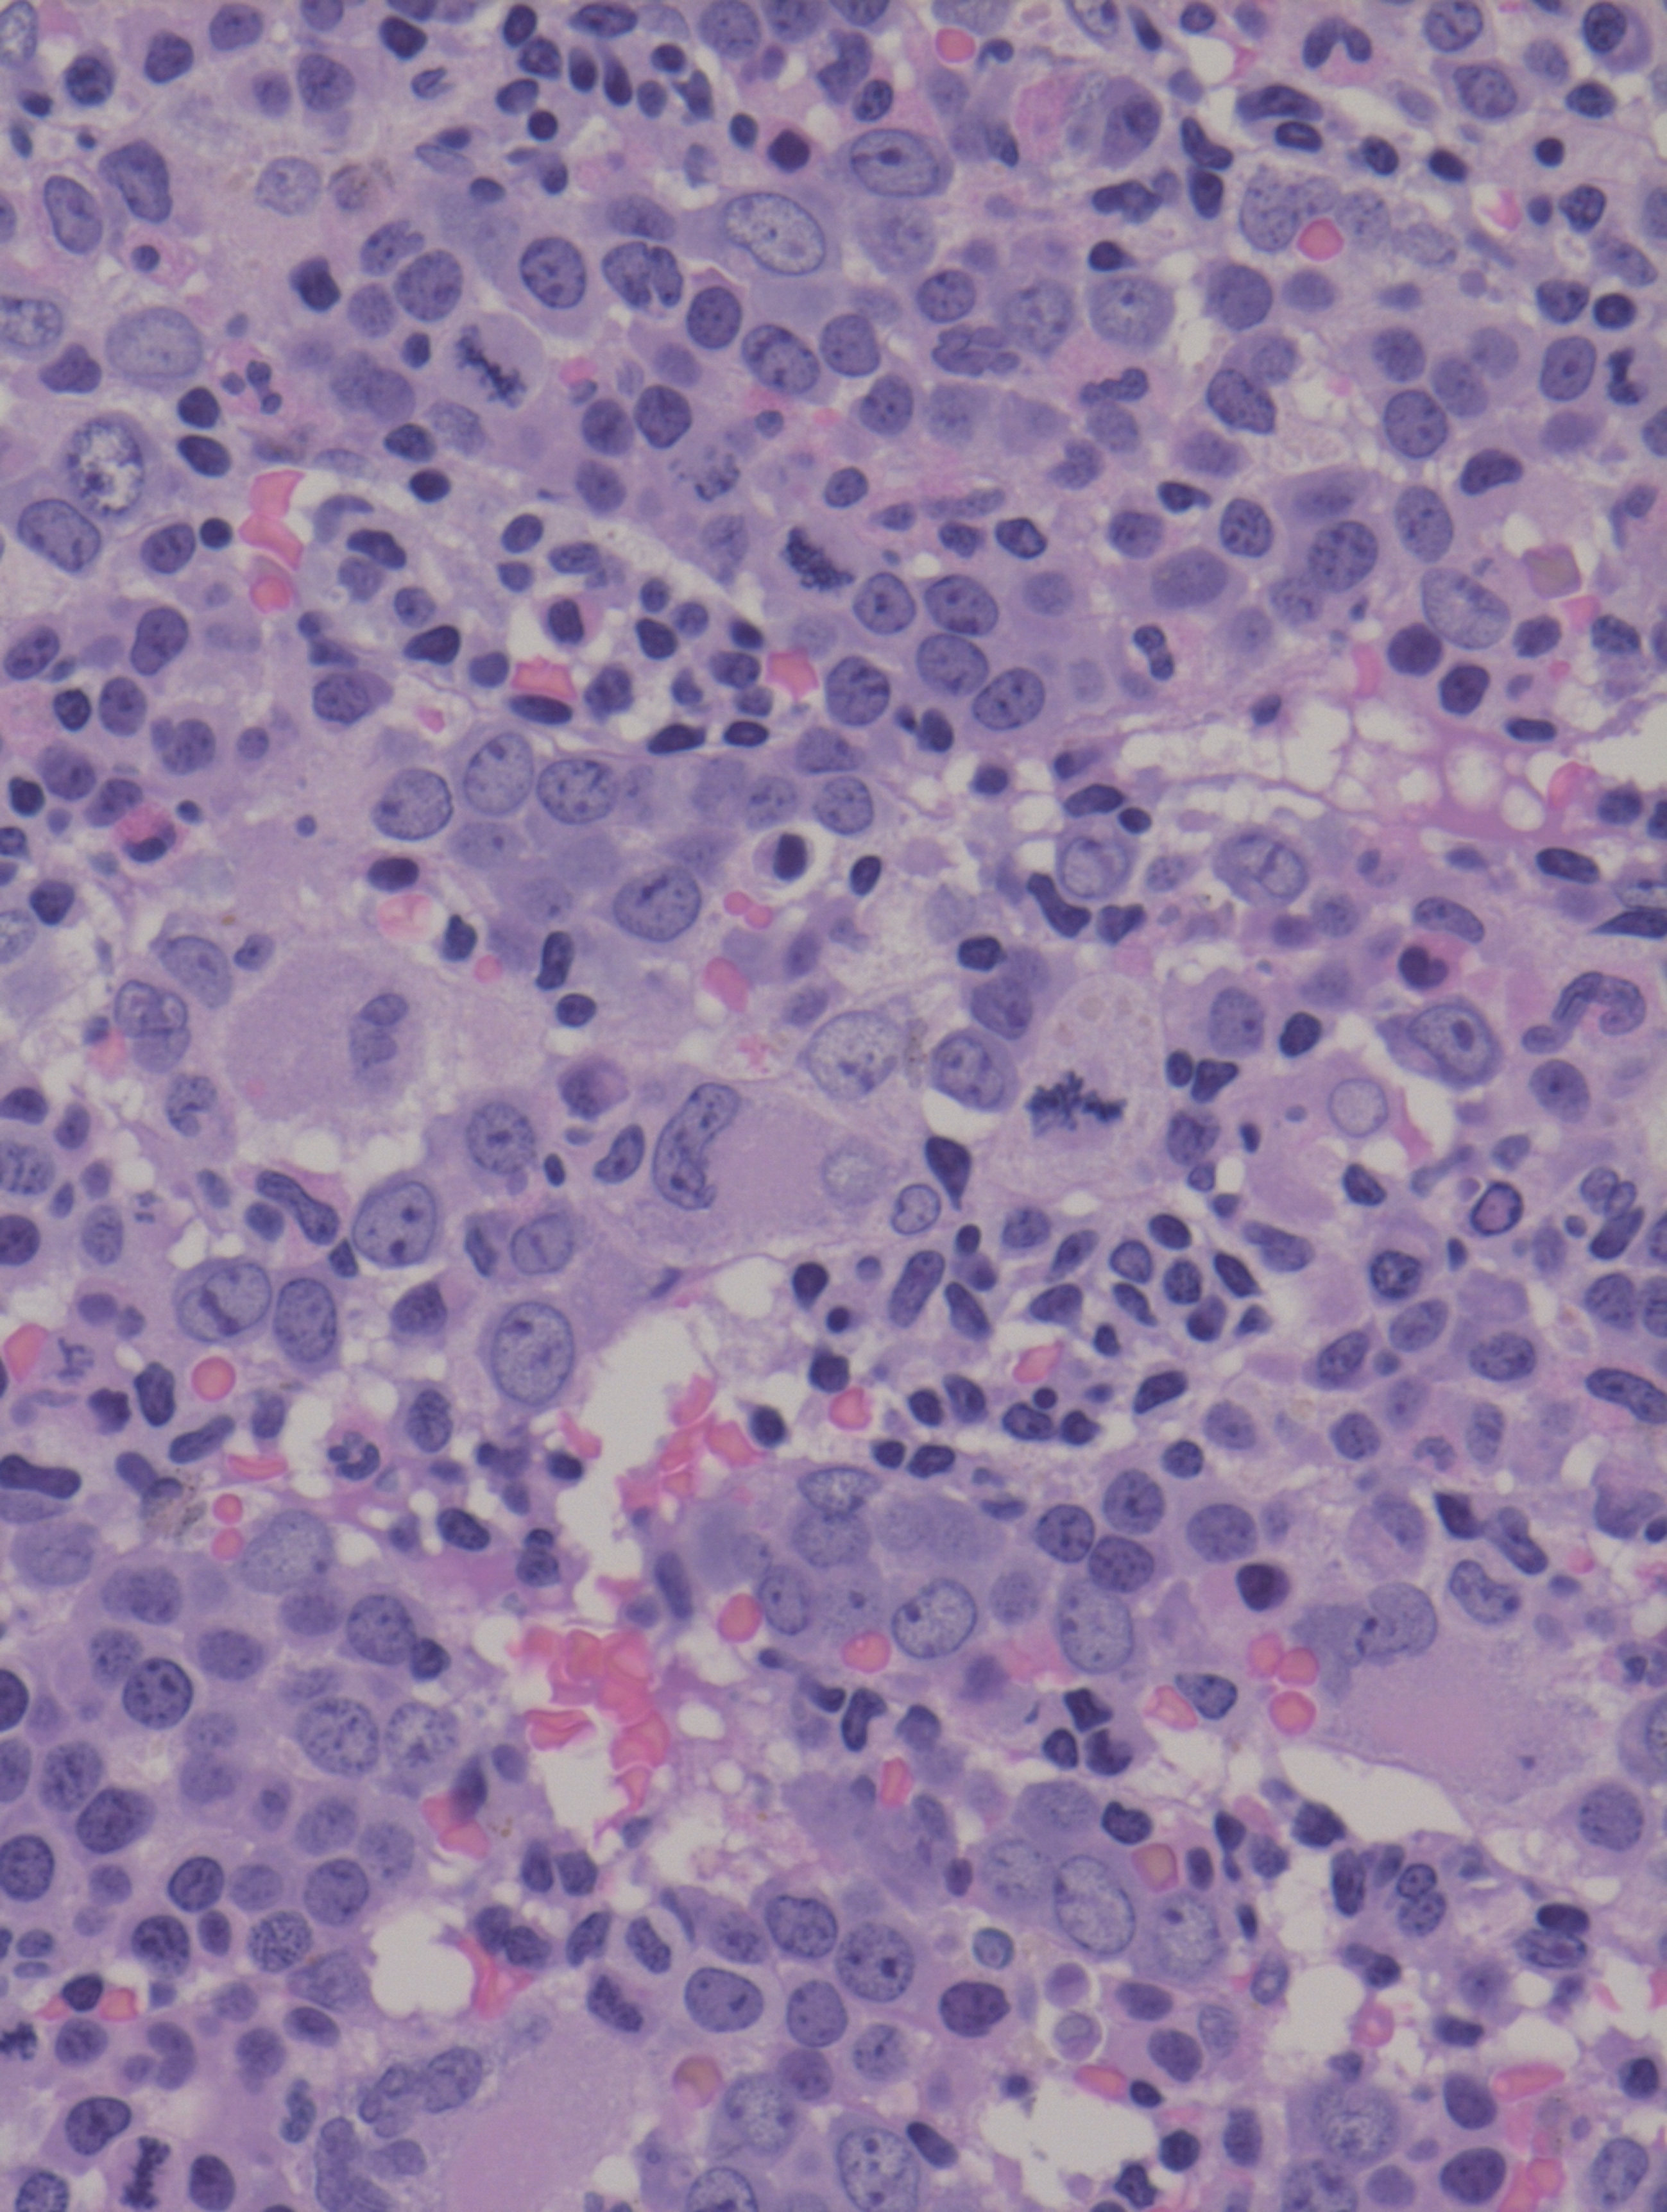
issue cover

Skip Nav Destination
Stroke prevention in Hispanic children with sickle cell anemia: the SACRED trial
Patient-reported improvements in paroxysmal nocturnal hemoglobinuria treated with iptacopan from 2 phase 3 studies
Final analysis of the phase 1b Chemotherapy and Venetoclax in Elderly Acute Myeloid Leukemia Trial (CAVEAT)
C3 as a predictive and prognostic biomarker in adult hemophagocytic lymphohistiocytosis: a large cohort study in China
Phase 1 study of CD19 CAR T-cell therapy harboring a fully human scFv in CAR-naïve adult patients with B-ALL
Acquired mutations in patients with relapsed/refractory CLL who progressed in the ALPINE study
Phase 1 study of quercetin, a natural antioxidant for children and young adults with Fanconi anemia
Characterizing the heterogeneity of Castleman disease and oligocentric subtype: findings from the ACCELERATE registry
Distress and symptom burden in patients with monoclonal gammopathy of undetermined significance and smoldering myeloma
Post transplant maintenance therapy with newly FDA-approved revumenib for high-risk KMT2Ar acute leukemia
Issue Archive
Table of Contents
INSIDE BLOOD ADVANCES
REVIEW ARTICLES
CLINICAL TRIALS AND OBSERVATIONS
Stroke prevention in Hispanic children with sickle cell anemia: the SACRED trial
Clinical Trials & Observations
Global Advances
Rosa M. Nieves,Teresa Latham,Nicolle Marte,Melissa Berges,Luisanna M. Sánchez,Gabriela Urcuyo,Carla Florencio,Carla Gonzalez,Paola del Villar,Sheena Chen,Daniel Ramirez,Paula Reyes,Manuel Marinez,Euladys Matos,Neelum D. Jeste,Susan E. Stuber,William H. Schultz,Adam C. Lane,Rafael Mena,Russell E. Ware
Patient-reported improvements in paroxysmal nocturnal hemoglobinuria treated with iptacopan from 2 phase 3 studies
Clinical Trials & Observations
Antonio M. Risitano,Carlos de Castro,Bing Han,Austin Kulasekararaj,Jaroslaw P. Maciejewski,Phillip Scheinberg,Yasutaka Ueda,Susan Vallow,Georgina Bermann,Marion Dahlke,Rakesh Kumar,Régis Peffault de Latour
Final analysis of the phase 1b Chemotherapy and Venetoclax in Elderly Acute Myeloid Leukemia Trial (CAVEAT)
Clinical Trials & Observations
Chong Chyn Chua,Sun Loo,Chun Yew Fong,Stephen B. Ting,Ing Soo Tiong,Shaun Fleming,Natasha S. Anstee,Adam Ivey,Michael Ashby,Tse-Chieh Teh,John Reynolds,Andrew W. Roberts,Andrew H. Wei
C3 as a predictive and prognostic biomarker in adult hemophagocytic lymphohistiocytosis: a large cohort study in China
Clinical Trials & Observations
Phase 1 study of CD19 CAR T-cell therapy harboring a fully human scFv in CAR-naïve adult patients with B-ALL
Clinical Trials & Observations
Jordan Gauthier,Emily C. Liang,Jennifer J. Huang,Erik L. Kimble,Alexandre V. Hirayama,Salvatore Fiorenza,Jenna M. Voutsinas,Qian (Vicky) Wu,Carla A. Jaeger-Ruckstuhl,Barbara S. Pender,Delaney R. Kirchmeier,Aiko Torkelson,Kristina Braathen,Ryan Basom,Mazyar Shadman,Noam E. Kopmar,Ryan D. Cassaday,Stanley R. Riddell,David G. Maloney,Cameron J. Turtle
Acquired mutations in patients with relapsed/refractory CLL who progressed in the ALPINE study
Clinical Trials & Observations
Jennifer R. Brown,Jessica Li,Barbara F. Eichhorst,Nicole Lamanna,Susan M. O’Brien,Constantine S. Tam,Lugui Qiu,Ruiqi Huang,Yang Shi,Adam Idoine,Tommi Salmi,Aileen Cleary Cohen,Mazyar Shadman
Phase 1 study of quercetin, a natural antioxidant for children and young adults with Fanconi anemia
Clinical Trials & Observations
Parinda A. Mehta,Adam Nelson,Sara Loveless,Adam Lane,Tsuyoshi Fukuda,Ashley Teusink-Cross,Deborah Elder,Denise Lagory,Erica Miller,Jose A. Cancelas,Jonathan Howell,Junfang Zhao,Kana Mizuno,Kasiani C. Myers,Kelly Lake,Kelly McIntosh,Kenneth D. R. Setchell,Nathan Luebbering,Stephanie Edwards,Tafadzwa Chihanga,Susanne I. Wells,Stella M. Davies
Characterizing the heterogeneity of Castleman disease and oligocentric subtype: findings from the ACCELERATE registry
Clinical Trials & Observations
Sheila K. Pierson,Joshua D. Brandstadter,Drew A. Torigian,Adam Bagg,Mary Jo Lechowicz,Daisy Alapat,Corey Casper,Amy Chadburn,Shanmuganathan Chandrakasan,Angela Dispenzieri,Alexander Fosså,Christian Hoffmann,Makoto Ide,Razelle Kurzrock,Sudipto Mukherjee,Sunita Nasta,José-Tomás Navarro,Ariela Noy,Eric Oksenhendler,Mateo Sarmiento Bustamante,Saishravan Shyamsundar,Matthew Streetly,Raymond S. M. Wong,Lu Zhang,Megan S. Lim,Gordan Srkalovic,Frits van Rhee,David C. Fajgenbaum
LYMPHOID NEOPLASIA
Large clones of clonal hematopoiesis affect outcome in mantle cell lymphoma: results from the FIL MCL0208 clinical trial
Simone Ragaini,Anna Galli,Elisa Genuardi,Martina Gandossini,Beatrice Alessandria,Aurora Maria Civita,Andrea Evangelista,Enrico Amaducci,Vittorio Stefoni,Federica Cavallo,Filippo Ballerini,Benedetta Puccini,Daniele Vallisa,Mariagrazia Michieli,Anna Pascarella,Angelo Palmas,Caterina Patti,Elisa Lucchini,Maria Grazia Careddu,Michele Merli,Massimiliano Postorino,Carola Boccomini,Monica Balzarotti,Vittorio Ruggero Zilioli,Maria Gomes da Silva,Benedetto Bruno,Ettore Rizzo,Marco Ladetto,Luca Malcovati,Simone Ferrero
Targeting the DNA damage response through TBL1X in mantle cell lymphoma
Betsy Pray,Ethan Baiocchi,Sydney Leon,Brian Barta,Shirsha Koirala,Liudmyla Tsyba,Claire Hinterschied,Jessika Carvajal-Moreno,Ian Hout,Shamama Nishat,Udita Jindal,Neeraj Jain,Satishkumar Singh,Lalit Sehgal,Wing Keung Chan,Walter Hanel,Jack Yalowich,Robert A. Baiocchi,Lapo Alinari
MYELOID NEOPLASIA
Deciphering the complex clonal heterogeneity of polycythemia vera and the response to interferon alfa
Milena Kalmer,Martin Grasshoff,Tiago Maié,Kristina Pannen,Marcelo A.S. Toledo,Margherita Vieri,Kathrin Olschok,Rebecca Lemanzyk,Jelena Lazarevic,Baerbel Junge,Julian Baumeister,Angela Galauner,Noa Chapal Ilani,Dror Bar,Elia Colin,Mingbo Cheng,Joelle Schifflers,Kim Kricheldorf,Mirle Schemionek,Tim H. Brümmendorf,Ralf Weiskirchen,Liran Shlush,Martin Zenke,Nicolas Chatain,Ivan G. Costa,Steffen Koschmieder
PLASMA CELL DISORDERS
PLATELETS AND THROMBOPOIESIS
Efficacy and safety of dapsone in adult primary immune thrombocytopenia
Marion Larue,Guillaume Moulis,Manuela Rueter,Sylvain Audia,Thibault Comont,Louis Terriou,Jean-François Viallard,Brigitte Pan-Petesch,Bruno Royer,Bernard Bonnotte,Lionel Galicier,Olivier Lambotte,François Lefrere,Stéphane Cheze,Mikael Ebbo,Tu-Ahn Duong,Emmanuelle Boutin,Laetitia Languille,Matthieu Mahevas,Bertrand Godeau,Florence Canoui-Poitrine,Marc Michel
THROMBOSIS AND HEMOSTASIS
TRANSPLANTATION
Posttransplant cyclophosphamide as GVHD prophylaxis in patients receiving mismatched unrelated HCT: the PHYLOS trial
Anna Maria Raiola,Benedetto Bruno,Antonio Maria Risitano,Federico Mosna,Irene Maria Cavattoni,Francesco Onida,Giorgia Saporiti,Francesca Patriarca,Marta Lisa Battista,Vincenzo Pavone,Anna Mele,Patrizia Chiusolo,Simona Sica,Barbara Loteta,Carmen di Grazia,Angelo Michele Carella,Dalila Salvatore,Enrico Morello,Alessandro Leoni,Luisa Giaccone,Paolo Bernasconi,Elisabetta Terruzzi,Nicola Mordini,Carlo Borghero,Francesco Zallio,Mario Luppi,Anna Grassi,Attilio Olivieri,Eugenia Piras,Nicoletta Sacchi,Giovannino Ciccone,Anna Castiglione,Eliana Degrandi,Emanuele Angelucci,Massimo Martino,Francesca Bonifazi
RESEARCH LETTERS
Primary cutaneous CD8+ aggressive epidermotropic cytotoxic T-cell lymphoma with novel FGFR1 fusion treated with pemigatinib
Carlos A. Torres-Cabala,Julia Arreola Yescas,Yue Zhang,Auris Huen,Gaur Sumit,Kristy Tefft,Guilin Tang,Jonathan L. Curry,Jillian Gunther,Bouthaina Dabaja,Swaminathan Iyer,Roberto N. Miranda,Jaehyuk Choi,Valentina Nardi
ICE polychemotherapy is an efficient salvage treatment in primary central nervous system lymphoma: an LOC network study
Louis Pérol,Adrien Grenier,Carole Soussain,Khê Hoang-Xuan,Inès Boussen,Marine Baron,Véronique Morel,Nabih Azar,Maya Ouzegdouh,Madalina Uzunov,Magali Le Garff-Tavernier,Laetitia Souchet,Nicolas Gauthier,Marie-Pierre Moles,Thomas Gastinne,Caroline Houillier,Sylvain Choquet,Damien Roos-Weil
Targeting RNA modification and mitochondrial metabolism cross talk in leukemic stem cells with CDK7 inhibitor TGN-1062
Hyunjun Kang,Lianjun Zhang,Mohan R. Kaadige,Melissa Valerio,Dinh Hoa Hoang,Trason Thode,Alexis Weston,Khyatiben Pathak,Lokesh Nigam,Nathanial P. Hansen,Brooke Lovell,Yuriy Shostak,Wei Li,Lucy Ghoda,Zhuo Li,Bin Zhang,Jianjun Chen,Patrick Pirrotte,Ya-Huei Kuo,Sunil Sharma,Guido Marcucci,Le Xuan Truong Nguyen
Distress and symptom burden in patients with monoclonal gammopathy of undetermined significance and smoldering myeloma
Clinical Trials & Observations
Elizabeth K. O’Donnell,Jennifer E. Carroll,Jaqueline Perry,Katherine Padgett,Benjamin Harris,Vidhi Patel,Omar Nadeem,Areej El-Jawahri,Irene M. Ghobrial,Catherine R. Marinac
COMMENTARY
Post transplant maintenance therapy with newly FDA-approved revumenib for high-risk KMT2Ar acute leukemia
Clinical Trials & Observations
Olayinka Okeleji,David McCall,Amber Gibson,Miriam B. Garcia,Cesar Nunez,Michael Roth,Jeremy Connors,Demetrios Petropoulos,Priti Tewari,Branko Cuglievan,Irtiza N. Sheikh
-
Cover Image
Cover Image
![issue cover]()
Bone marrow biopsy core shows relative hypercellularity with dilated sinuses containing bland-appearing small lymphocytes (hematoxylin and eosin stain; image magnified 40×). See the article by Schwartz et al.
Advertisement intended for health care professionals
Advertisement intended for health care professionals

Sickle cell care and implementation science
Clinical Trials & Observations